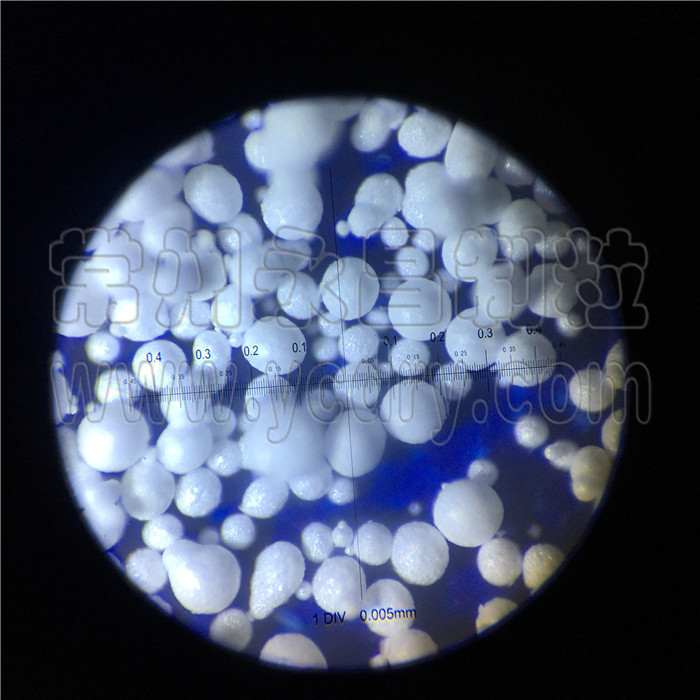
246天天免费资料网

江苏省常州市金坛区儒林镇园区西路98号7幢
邮编:213116
联系人:成经理
手机:13806126909
电话:0519-88911909 88912909
传真:0519-88913909
邮箱:[email protected]
网址:
特陶颗粒100-300um球形制粒机,山东某化工试机,压力喷雾造粒机
压力喷雾造粒干燥机(液体干燥成空心或实心球形颗粒)
免费提供试验设备,提供100ml以上可试料,进风温度100-260度。也可做中试生产或代加工。